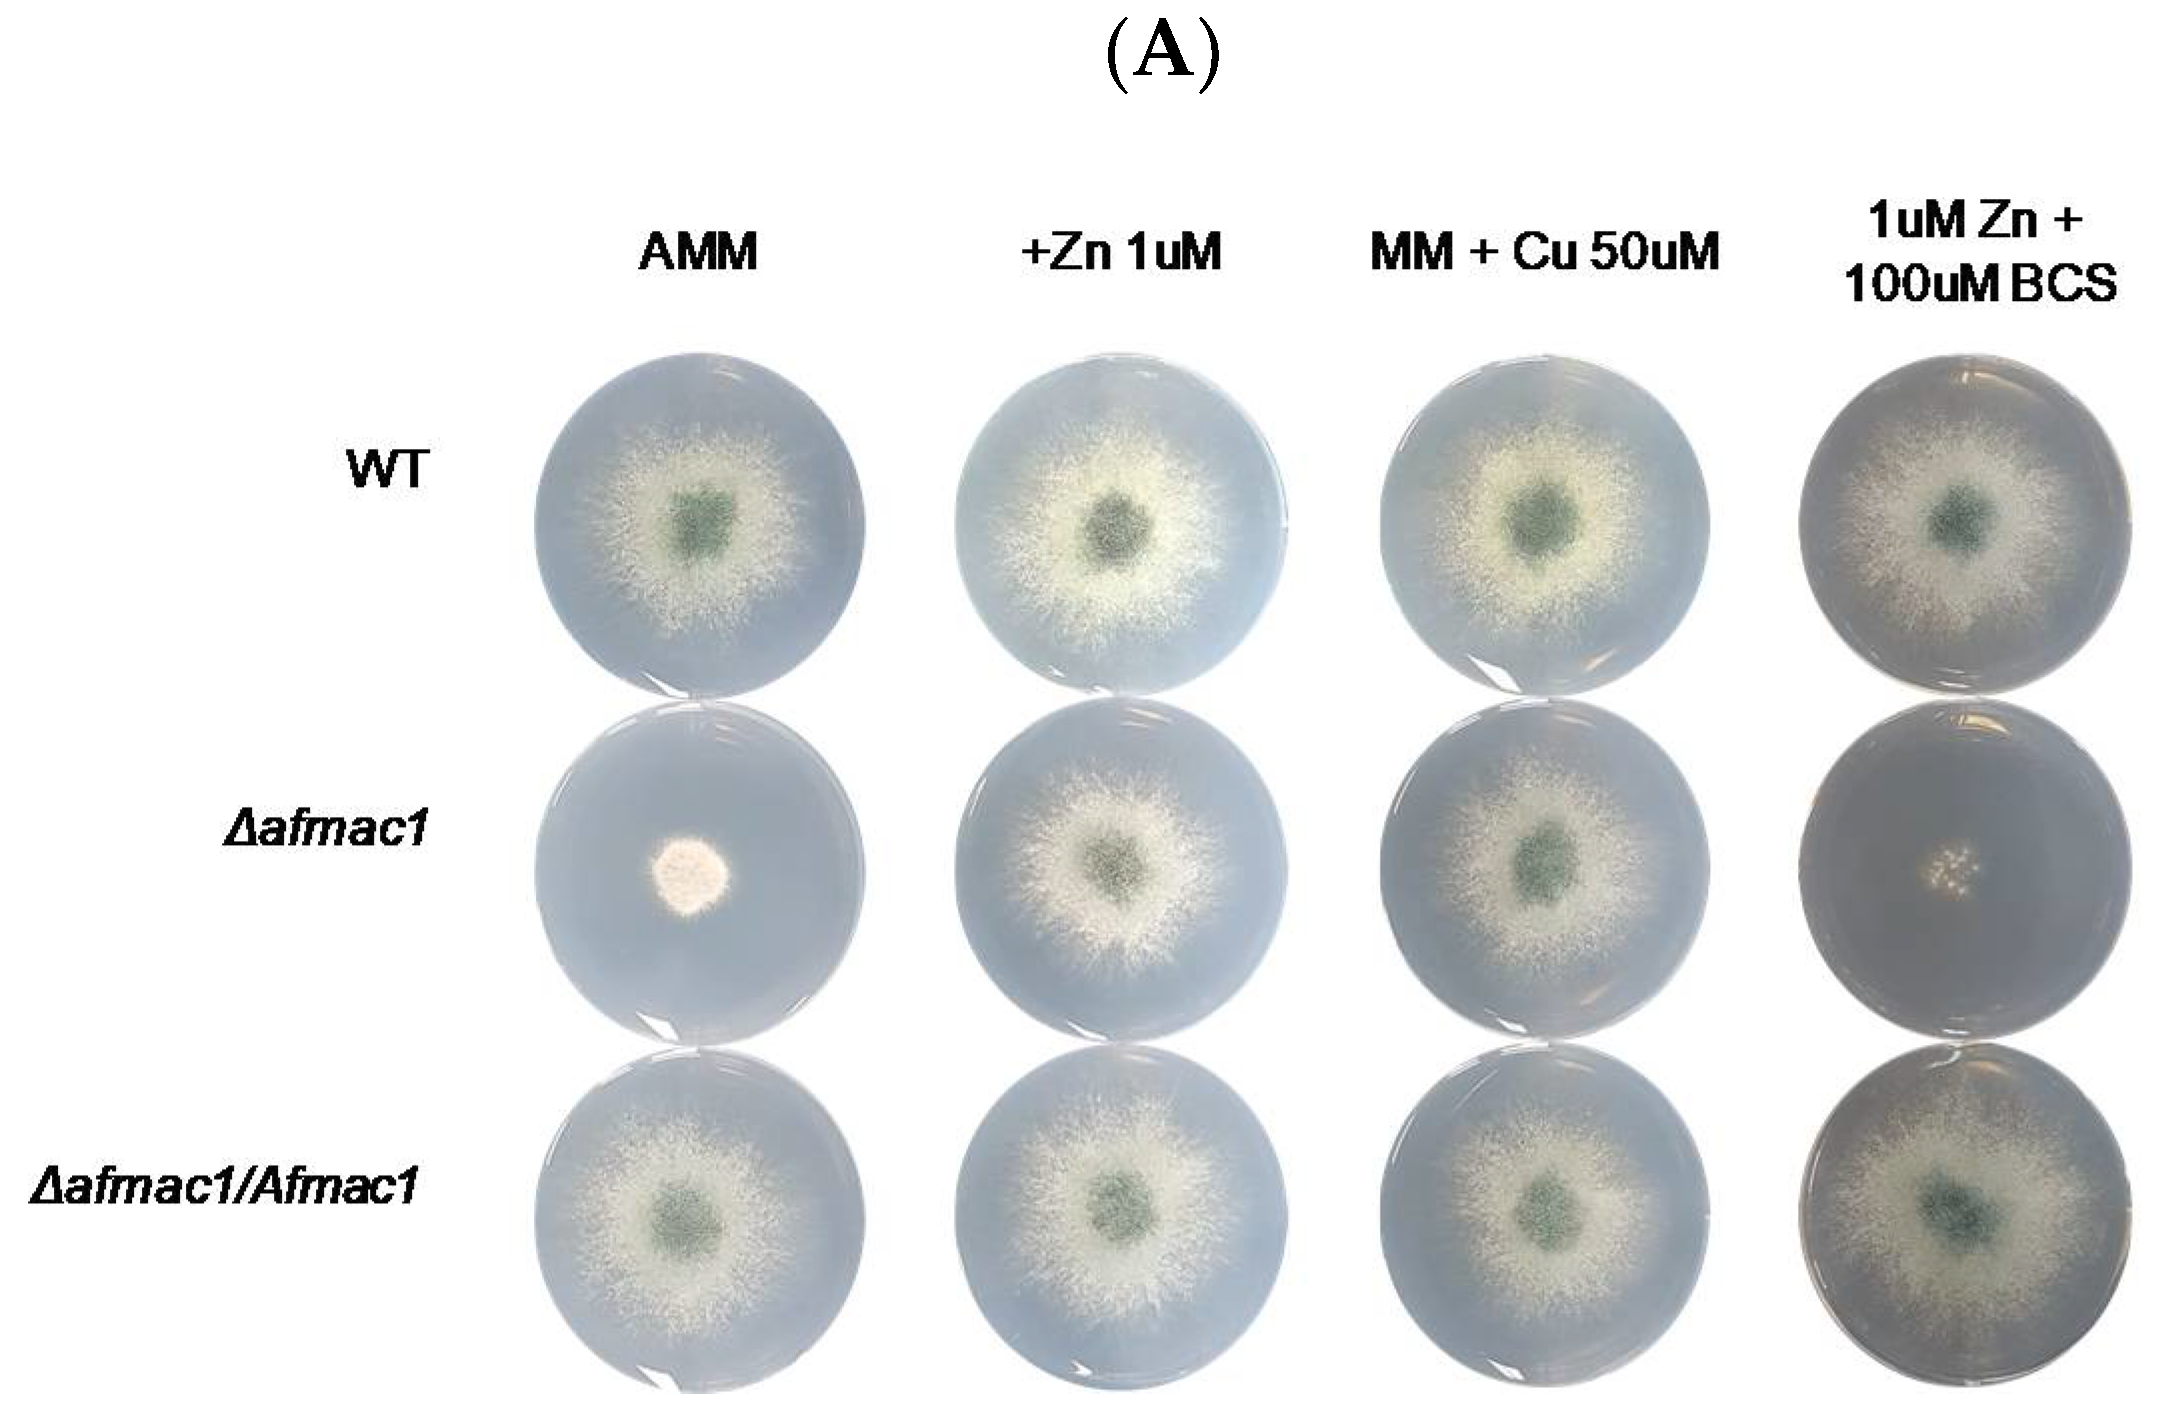
Ijms 21 07665 g001a Ijms 21 07665 g001a

The Role of Zinc in Copper Homeostasis of Aspergillus fumigatus
Abstract
1. Introduction
2. Results
2.1. Growth Defect of the Δafmac1 Strain was Recovered by Zinc Starvation
2.2. The Expression of Genes that Encode Copper Transporters Was Regulated by Zinc
2.3. ZafA Regulates the Expression of Ctr Genes via the ZafA Binding Motif
2.4. ZafA Binds to the ZafA Binding Motif of the CtrC Promoter Region, and the Binding Affinity Is Inversely Related to Zinc and Copper Concentration
3. Discussion
4. Materials and Methods
4.1. Strains, Media, and Plasmids
4.2. Site-Directed Mutagenesis
4.3. Plate Assay
4.4. Northern Blot Assay
4.5. β-Galactosidase Assay
4.6. ZafA Protein Purification
4.7. Electrophoretic Mobility Shift Assay (EMSA)
Supplementary Materials
Author Contributions
Funding
Acknowledgments
Conflicts of Interest
References
- Gerwien, F.; Skrahina, V.; Kasper, L.; Hube, B.; Brunke, S. Metals in fungal virulence. Fems Microbiol. Rev. 2018, 42, fux050. [Google Scholar] [CrossRef] [PubMed]
- Porcheron, G.; Garénaux, A.; Proulx, J.; Sabri, M.; Dozois, C.M. Iron, copper, zinc, and manganese transport and regulation in pathogenic Enterobacteria: Correlations between strains, site of infection and the relative importance of the different metal transport systems for virulence. Front. Cell. Infect. Microbiol. 2013. [Google Scholar] [CrossRef] [PubMed]
- Ding, C.; Festa, R.A.; Sun, T.S.; Wang, Z.Y. Iron and copper as virulence modulators in human fungal pathogens. Mol. Microbiol. 2014, 93, 10–23. [Google Scholar] [CrossRef]
- Nam, E.; Han, J.; Suh, J.-M.; Yi, Y.; Lim, M.H. Link of impaired metal ion homeostasis to mitochondrial dysfunction in neurons. Curr. Opin. Chem. Biol. 2018, 43, 8–14. [Google Scholar] [CrossRef] [PubMed]
- Winterbourn, C.C. Toxicity of iron and hydrogen peroxide: The Fenton reaction. Toxicol. Lett. 1995, 82–83, 969–974. [Google Scholar] [CrossRef]
- Nerud, F.; Baldrian, P.; Gabriel, J.; Ogbeifun, D. Decolorization of synthetic dyes by the Fenton reagent and the Cu/pyridine/H2O2 system. Chemosphere 2001, 44, 957–961. [Google Scholar] [CrossRef]
- Klein, J.S.; Lewinson, O. Bacterial ATP-driven transporters of transition metals: Physiological roles, mechanisms of action, and roles in bacterial virulence. Metallomics 2011. [Google Scholar] [CrossRef]
- Hissen, A.H.T.; Wan, A.N.C.; Warwas, M.L.; Pinto, L.J.; Moore, M.M. The Aspergillus fumigatus Siderophore Biosynthetic Gene sidA, Encoding l-Ornithine N(5)-Oxygenase, Is Required for Virulence. Infect. Immun. 2005, 73, 5493–5503. [Google Scholar] [CrossRef]
- Amich, J.; Vicentefranqueira, R.; Mellado, E.; Ruiz-Carmuega, A.; Leal, F.; Calera José, A. The ZrfC alkaline zinc transporter is required for Aspergillus fumigatus virulence and its growth in the presence of the Zn/Mn-chelating protein calprotectin. Cell. Microbiol. 2013, 16, 548–564. [Google Scholar] [CrossRef]
- Upadhyay, S.; Torres, G.; Lin, X. Laccases involved in 1,8-dihydroxynaphthalene melanin biosynthesis in Aspergillus fumigatus are regulated by developmental factors and copper homeostasis. Eukaryot. Cell 2013, 12, 1641–1652. [Google Scholar] [CrossRef]
- Park, Y.-S.; Kim, T.-H.; Yun, C.-W. Functional characterization of the copper transcription factor AfMac1 from Aspergillus fumigatus. Biochem. J. 2017, 474, 2365. [Google Scholar] [CrossRef] [PubMed]
- Plante, S.; Normant, V.; Ramos-Torres, K.M.; Labbé, S. Cell-surface copper transporters and superoxide dismutase 1 are essential for outgrowth during fungal spore germination. J. Biol. Chem. 2017. [Google Scholar] [CrossRef] [PubMed]
- Kusuya, Y.; Hagiwara, D.; Sakai, K.; Yaguchi, T.; Gonoi, T.; Takahashi, H. Transcription factor Afmac1 controls copper import machinery in Aspergillus fumigatus. Curr. Genet. 2017, 63, 777–789. [Google Scholar] [CrossRef] [PubMed]
- Cai, Z.; Du, W.; Zeng, Q.; Long, N.; Dai, C.; Lu, L. Cu-sensing transcription factor Mac1 coordinates with the Ctr transporter family to regulate Cu acquisition and virulence in Aspergillus fumigatus. Fungal Genet. Biol. 2017, 107, 31–43. [Google Scholar] [CrossRef]
- Park, Y.-S.; Lian, H.; Chang, M.; Kang, C.-M.; Yun, C.-W. Identification of high-affinity copper transporters in Aspergillus fumigatus. Fungal Genet. Biol. 2014, 73, 29–38. [Google Scholar] [CrossRef]
- McDaniels, C.P.J.; Jensen Lt Fau-Srinivasan, C.; Srinivasan C Fau-Winge, D.R.; Winge Dr Fau-Tullius, T.D.; Tullius, T.D. The yeast transcription factor Mac1 binds to DNA in a modular fashion. J. Biol. Chem. 1999. [Google Scholar] [CrossRef]
- Keller, G.; Gross, C.; Fau-Kelleher, M.; Kelleher, M.; Fau-Winge, D.R.; Winge, D.R. Functional independence of the two cysteine-rich activation domains in the yeast Mac1 transcription factor. J. Biol. Chem. 2000. [Google Scholar] [CrossRef]
- Riggle, P.J.; Kumamoto, C.A. Role of a Candida albicans P1-Type ATPase in Resistance to Copper and Silver Ion Toxicity. J. Bacteriol. 2000, 182, 4899. [Google Scholar] [CrossRef]
- Antsotegi-Uskola, M.; Markina-Iñarrairaegui, A.; Ugalde, U. Copper Resistance in Aspergillus nidulans Relies on the PI-Type ATPase CrpA, Regulated by the Transcription Factor AceA. Front. Microbiol. 2017, 8. [Google Scholar] [CrossRef]
- Cai, Z.; Du, W.; Zhang, Z.; Guan, L.; Zeng, Q.; Chai, Y.; Dai, C.; Lu, L. The Aspergillus fumigatus transcription factor AceA is involved not only in Cu but also in Zn detoxification through regulating transporters CrpA and ZrcA. Cell. Microbiol. 2018. [Google Scholar] [CrossRef]
- Andreini, C.; Banci, L.; Bertini, I.; Rosato, A. Counting the Zinc-Proteins Encoded in the Human Genome. J. Proteome Res. 2006, 5, 196–201. [Google Scholar] [CrossRef] [PubMed]
- Andreini, C.; Bertini, I.; Cavallaro, G.; Holliday, G.L.; Thornton, J.M. Metal ions in biological catalysis: From enzyme databases to general principles. JBIC J. Biol. Inorg. Chem. 2008, 13, 1205–1218. [Google Scholar] [CrossRef] [PubMed]
- Kambe, T.; Tsuji, T.; Hashimoto, A.; Itsumura, N. The Physiological, Biochemical, and Molecular Roles of Zinc Transporters in Zinc Homeostasis and Metabolism. Physiol. Rev. 2015, 95, 749–784. [Google Scholar] [CrossRef] [PubMed]
- Maares, M.; Haase, H. Zinc and immunity: An essential interrelation. Arch. Biochem. Biophys. 2016. [Google Scholar] [CrossRef]
- Zhao, H.; Eide, D. The yeast ZRT1 gene encodes the zinc transporter protein of a high-affinity uptake system induced by zinc limitation. Proc. Natl. Acad. Sci. USA 1996, 93, 2454–2458. [Google Scholar] [CrossRef]
- Vicentefranqueira, R.; Moreno, M.Á.; Leal, F.; Calera, J.A. The zrfA and zrfB Genes of Aspergillus fumigatus Encode the Zinc Transporter Proteins of a Zinc Uptake System Induced in an Acid, Zinc-Depleted Environment. Eukaryot. Cell 2005, 4, 837–848. [Google Scholar] [CrossRef]
- Miyabe, S.; Izawa, S.; Inoue, Y. Expression of ZRC1 Coding for Suppressor of Zinc Toxicity Is Induced by Zinc-starvation Stress in Zap1-Dependent Fashion in Saccharomyces cerevisiae. Biochem. Biophys. Res. Commun. 2000, 276, 879–884. [Google Scholar] [CrossRef] [PubMed]
- Amich, J.; Calera, J.A. Zinc Acquisition: A Key Aspect in Aspergillus fumigatus Virulence. Mycopathologia 2014, 178, 379–385. [Google Scholar] [CrossRef]
- Lu, M.; Chai, J.; Fu, D. Structural basis for autoregulation of the zinc transporter YiiP. Nat. Struct. Mol. Biol. 2009, 16, 1063–1067. [Google Scholar] [CrossRef]
- Vicentefranqueira, R.; Amich, J.; Marín, L.; Sánchez, C.; Leal, F.; Calera, J. The Transcription Factor ZafA Regulates the Homeostatic and Adaptive Response to Zinc Starvation in Aspergillus fumigatus. Genes 2018, 9, 318. [Google Scholar] [CrossRef]
- Frey, A.G.; Bird, A.J.; Evans-Galea, M.V.; Blankman, E.; Winge, D.R.; Eide, D.J. Zinc-Regulated DNA Binding of the Yeast Zap1 Zinc-Responsive Activator. PLoS ONE 2011, 6, e22535. [Google Scholar] [CrossRef] [PubMed]
- Amich, J.; Leal, F.; Calera, J.A. Repression of the acid ZrfA/ZrfB zinc-uptake system of Aspergillus fumigatus mediated by PacC under neutral, zinc-limiting conditions. Int. Microbiol. 2009, 12, 39–47. [Google Scholar]
- Latgé, J.-P.; Chamilos, G. Aspergillus fumigatus and aspergillosis in 2019. Clin. Microbiol. Rev. 2019, 33, e00140-00118. [Google Scholar] [CrossRef] [PubMed]
- Hood, M.I.; Skaar, E.P. Nutritional immunity: Transition metals at the pathogen–host interface. Nat. Rev. Microbiol. 2012, 10, 525. [Google Scholar] [CrossRef]
- Hennigar, S.R.; McClung, J.P. Nutritional Immunity: Starving Pathogens of Trace Minerals. Am. J. Lifestyle Med. 2016, 10, 170–173. [Google Scholar] [CrossRef]
- Wiemann, P.; Perevitsky, A.; Lim, F.Y.; Shadkchan, Y.; Knox, B.P.; Landero Figueora, J.A.; Choera, T.; Niu, M.; Steinberger, A.J.; Wüthrich, M.; et al. Aspergillus fumigatus Copper Export Machinery and Reactive Oxygen Intermediate Defense Counter Host Copper-Mediated Oxidative Antimicrobial Offense. Cell Rep. 2017, 19, 1008–1021. [Google Scholar] [CrossRef]
- García-Santamarina, S.; Thiele, D.J. Copper at the Fungal Pathogen-Host Axis. J. Biol. Chem. 2015, 290, 18945–18953. [Google Scholar] [CrossRef]
- White, C.; Lee, J.; Kambe, T.; Fritsche, K.; Petris, M.J. A Role for the ATP7A Copper-transporting ATPase in Macrophage Bactericidal Activity. J. Biol. Chem. 2009, 284, 33949–33956. [Google Scholar] [CrossRef]
- Corbin, B.D.; Seeley, E.H.; Raab, A.; Feldmann, J.; Miller, M.R.; Torres, V.J.; Anderson, K.L.; Dattilo, B.M.; Dunman, P.M.; Gerads, R.; et al. Metal Chelation and Inhibition of Bacterial Growth in Tissue Abscesses. Science 2008, 319, 962. [Google Scholar] [CrossRef]
- Park, Y.S.; Kang, S.; Seo, H.; Yun, C.W. A copper transcription factor, AfMac1, regulates both iron and copper homeostasis in the opportunistic fungal pathogen Aspergillus fumigatus. Biochem. J. 2018. [Google Scholar] [CrossRef]
- Yap, A.; Misslinger, M.; Haas, H. Absent regulation of iron acquisition by the copper regulator Mac1 in A. fumigatus. Biochem. J. 2020. [Google Scholar] [CrossRef]
- Cobine, P.A.; George, G.N.; Jones, C.E.; Wickramasinghe, W.A.; Solioz, M.; Dameron, C.T. Copper Transfer from the Cu(I) Chaperone, CopZ, to the Repressor, Zn(II)CopY: Metal Coordination Environments and Protein Interactions. Biochemistry 2002, 41, 5822–5829. [Google Scholar] [CrossRef] [PubMed]
- Waters, B.M.; Eide, D.J. Combinatorial Control of Yeast FET4 Gene Expression by Iron, Zinc, and Oxygen. J. Biol. Chem. 2002, 277, 33749–33757. [Google Scholar] [CrossRef] [PubMed]
- Oestreicher, P.; Cousins, R.J. Copper and Zinc Absorption in the Rat: Mechanism of Mutual Antagonism. J. Nutr. 1985, 115, 159–166. [Google Scholar] [CrossRef] [PubMed]
- de Figueiredo, C.S.M.; Palhares, D.B.; Melnikov, P.; da Cruz Montes Moura, A.J.; dos Santos, S.C. Zinc and Copper Concentrations in Human Preterm Milk. Biol. Trace Elem. Res. 2010, 136, 1–7. [Google Scholar] [CrossRef]
- Griffin, I.J.; Domellöf, M.; Bhatia, J.; Anderson, D.M.; Kler, N. Zinc and copper requirements in preterm infants: An examination of the current literature. Early Hum. Dev. 2013, 89, S29–S34. [Google Scholar] [CrossRef]
- Leung, P.L.; Li, X.L. The changes of metabolism balance of zinc and copper in gastric juice with widely varying dietary zinc intake. Biol. Trace Elem. Res. 1993, 39, 33–39. [Google Scholar] [CrossRef]
- Hoogenraad, T.U. Paradigm shift in treatment of Wilson’s disease: Zinc therapy now treatment of choice. Brain Dev. 2006, 28, 141–146. [Google Scholar] [CrossRef]
- Milne, D.B.; Davis, C.D.; Nielsen, F.H. Low dietary zinc alters indices of copper function and status in postmenopausal women. Nutrition 2001, 17, 701–708. [Google Scholar] [CrossRef]
- Liang, Z.D.; Tsai, W.-B.; Lee, M.-Y.; Savaraj, N.; Kuo, M.T. Specificity Protein 1 (Sp1) Oscillation Is Involved in Copper Homeostasis Maintenance by Regulating Human High-Affinity Copper Transporter 1 Expression. Mol. Pharmacol. 2012, 81, 455. [Google Scholar] [CrossRef]
- Clark, H.L.; Jhingran, A.; Sun, Y.; Vareechon, C.; de Jesus Carrion, S.; Skaar, E.P.; Chazin, W.J.; Calera, J.A.; Hohl, T.M.; Pearlman, E. Zinc and Manganese Chelation by Neutrophil S100A8/A9 (Calprotectin) Limits Extracellular Aspergillus fumigatus Hyphal Growth and Corneal Infection. J. Immunol. 2016, 196, 336. [Google Scholar] [CrossRef] [PubMed]
- Expert, D. Withholding and Exchanging Iron: Interactions Between Erwinia spp. and Their Plant Hosts. Annu. Rev. Phytopathol. 1999. [Google Scholar] [CrossRef] [PubMed]
- Geiser, D.L.; Winzerling, J.J. Insect transferrins: Multifunctional proteins. Biochim. Biophys. Acta (BBA)-Gen. Subj. 2012, 1820, 437–451. [Google Scholar] [CrossRef] [PubMed]
- McCormick, A.; Heesemann, L.; Wagener, J.; Marcos, V.; Hartl, D.; Loeffler, J.; Heesemann, J.; Ebel, F. NETs formed by human neutrophils inhibit growth of the pathogenic mold Aspergillus fumigatus. Microbes Infect. 2010, 12, 928–936. [Google Scholar] [CrossRef] [PubMed]
- Seo, H.A.-O.; Kang, S.; Park, Y.S.; Yun, C.W. The Role of Zinc in Gliotoxin Biosynthesis of Aspergillus fumigatus. Int. J. Mol. Sci. 2019, 20, 6192. [Google Scholar] [CrossRef]
- Tischler, B.Y.; Hohl, T.M. Menacing Mold: Recent Advances in Aspergillus Pathogenesis and Host Defense. J. Mol. Biol. 2019, 431, 4229–4246. [Google Scholar] [CrossRef]
- van de Veerdonk, F.L.; Gresnigt, M.S.; Romani, L.; Netea, M.G.; Latgé, J.P. Aspergillus fumigatus morphology and dynamic host interactions. Nat. Rev. Microbiol. 2017. [Google Scholar] [CrossRef]

Publisher’s Note: MDPI stays neutral with regard to jurisdictional claims in published maps and institutional affiliations. |
© 2020 by the authors. Licensee MDPI, Basel, Switzerland. This article is an open access article distributed under the terms and conditions of the Creative Commons Attribution (CC BY) license (http://creativecommons.org/licenses/by/4.0/).
Share and Cite
Kang, S.; Seo, H.; Moon, H.-S.; Kwon, J.-H.; Park, Y.-S.; Yun, C.-W. The Role of Zinc in Copper Homeostasis of Aspergillus fumigatus. Int. J. Mol. Sci. 2020, 21, 7665. https://doi.org/10.3390/ijms21207665
Kang S, Seo H, Moon H-S, Kwon J-H, Park Y-S, Yun C-W. The Role of Zinc in Copper Homeostasis of Aspergillus fumigatus. International Journal of Molecular Sciences. 2020; 21(20):7665. https://doi.org/10.3390/ijms21207665
Chicago/Turabian StyleKang, Suzie, Hyewon Seo, Hee-Soo Moon, Joon-Ho Kwon, Yong-Sung Park, and Cheol-Won Yun. 2020. "The Role of Zinc in Copper Homeostasis of Aspergillus fumigatus" International Journal of Molecular Sciences 21, no. 20: 7665. https://doi.org/10.3390/ijms21207665
APA StyleKang, S., Seo, H., Moon, H.-S., Kwon, J.-H., Park, Y.-S., & Yun, C.-W. (2020). The Role of Zinc in Copper Homeostasis of Aspergillus fumigatus. International Journal of Molecular Sciences, 21(20), 7665. https://doi.org/10.3390/ijms21207665




